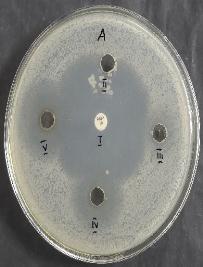
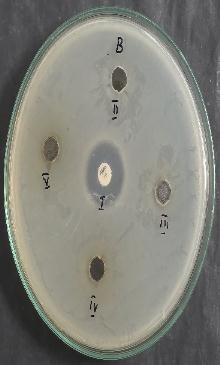

International Research Journal of Engineering and Technology (IRJET) e-ISSN: 2395-0056
Volume: 13 Issue: 01 | Jan 2026 www.irjet.net p-ISSN: 2395-0072
![]()

International Research Journal of Engineering and Technology (IRJET) e-ISSN: 2395-0056
Volume: 13 Issue: 01 | Jan 2026 www.irjet.net p-ISSN: 2395-0072
Dr. T. SAHAYA MARIA JEYASEELI*
*Assistant Professor, Department of Chemistry, TDMNS College, T.Kallikulam, Affiliated to Manonmaniam Sundaranar University, Tirunelveli, Tamilnadu, India.
Abstract - Green synthesis of nanoparticles using plant extracts has emerged as a sustainable alternative to conventional chemical methods. This study focuses on the preparation and antimicrobial evaluation of nanoparticles synthesizedusinggarlic(Alliumsativum)extractasanatural reducing and stabilizing agent. Garlic contains bioactive compounds such as allicin, organo sulfur molecules, and flavonoids, which facilitate nanoparticles formation and contribute to their biological activity. The synthesized nanoparticles were characterized using UV–Visible spectroscopy, and FTIR to confirm particle formation, functional group interactions. Antimicrobial activity was assessed against selected Gram-positive and Gram-negative bacterial strains using agar well diffusion techniques. The garlic-mediated nanoparticles demonstrated significantly higherantimicrobialactivitycomparedtocrudegarlicextract, suggesting that nanoscale size and enhanced surface reactivityimprovetheirinteractionwithmicrobialcells
Key Words: Nanoparticles, Bioactive compound, UVVisible, Diffusion, Microbial, Flavonoids, Synthesis
1. INTRODUCTION
The evolution of nanotechnology has attracted young researchers towards eco-friendly biosynthesis of nanoparticles.Plantextractscontainingbiomoleculescanbe usedtoreducemetalionstonanoparticles.Thereductionof metalionscanbecarriedout readily atroomtemperature and pressure, and easily scaled up[1].These findings highlightthepotential ofgarlic-mediatednanoparticlesas efficient antimicrobial agents suitable for biomedical, pharmaceutical,andfood-safetyapplications.[2]Thegreen synthesisapproachalsooffersadvantagessuchassimplicity, cost-effectiveness, and environmental safety. Overall, this studysupportsthedevelopmentofplant-basednanoparticle synthesis as a promising alternative to traditional antimicrobial strategies. Further research on toxicity assessment,stability,andapplication-specificoptimizationis recommendedtoexpandtheirpracticaluse.
2. EXPERIMENTAL
2.1. Materials
Copper sulphate, distilled water (all at high laboratory standard)wereusedinthisstudy, Alliumsativumextract
was used as the reducing agent for the preparation of the
copper nanoparticleswhichwasalsousedasthestabilizer forthenewlysynthesizednanosizedcoppercolloids,Muffle furnace,Hotairoven,MortarandPestle.
2.2.1 Preparation of the extract of Allium sativum and the synthesis of copper nanoparticles:
AqueousextractofAlliumsativumwaspreparedusingfresh bulbs of garlic (10 g) which were collected from local market.Thesurfacesofthebulbswerecleanedwithrunning tap water followed by distilled water and subsequently boiled in 100 ml distilled water at 120° C for 10 min. The extractwasfilteredthroughWhatmanNo.1filterpaperand filtratewascollected.
2.2.2 Synthesis of the Copper Nanoparticles:
Copper sulphate solution was prepared using 100 ml of deionizedwater.To50mlofabovesolution,50mlofextract of Allium sativum was added and placed in the magnetic stirrerat40°Cturnedfor3hours. Thecolourofthesolution turnedfromdark green to palegreen whichindicated the formationofnanoparticles.Theformedcoppernanoparticles were dried at 100° C for an hour. Dried green coloured copper nanoparticleswerecollectedandstoredinairtight container.
3.1. ULTRAVIOLET VISIBLE
UV–visibleabsorptionspectrumofcoppernanoparticleis shown in Figure 1. The characteristic absorption peak at around 575 nm is due to the surface plasmon band of Cu colloids [3]. The strong surface plasmon absorption band observed at 575 nm may be due to the formation of nonoxidized Cu NPs. The broadness of the absorption band probably arises from the wide size distribution of copper nanoparticles.

International Research Journal of Engineering and Technology (IRJET) e-ISSN: 2395-0056
Volume: 13 Issue: 01 | Jan 2026 www.irjet.net p-ISSN: 2395-0072

FT-IR spectroscopy, a type of vibrational spectroscopy, is usedtoidentifythestretchingandbendingfrequencies of molecularfunctionalgroupsattachedtoCuNPsurface. The FTIR spectrum of biosynthesized Cu NPs is presented in Figure.2 Which shows a number of absorption peaks at differentIRfrequencies. Broadbandsataround3200-3600 cm-1, 1600-1800 cm-1 and 2400 cm-1 attribute for the presenceof(OH)stretchingof phenolicgroup,(>C=O)and (>NH) stretching. Hence, FTIR spectra of copper nanoparticles confirmed the presence of various biomoleculessuchassaponins,tannins,flavonoids,alkaloids and polyphenols etc. surrounding Copper nanoparticles which are responsible for reduction as well as in the stabilizationofnanoparticles[4]

Toassesstheantimicrobialactivityofthedrug,100mgofthe synthesized nanoparticle was dissolved in 1ml of DMSO, mixingthoroughlyuntilthedrugwascompletelydissolved. Thisstocksolutionwasthenusedtopreparetestsamplesat concentrations of 10, 20, 40, and 60 micrograms (µg) for antimicrobialassays.Theantimicrobialactivityofthesample was evaluated using a well diffusion assay against three microorganisms:A) Limosilactobacillus fermentum,B) Escherichia coli, andC) Candida albicans[5].Preparation of CultureBroth: Nutrient broth was prepared by dissolving 13g per litre in the required volume and sterilised using standardautoclavingmethods.Thetargetmicroorganisms wereinoculatedintothesterilized brothandincubated at 37°Cfor24hours.
Theantimicrobialactivityofthesamplewasassessedusinga well diffusion assay. Mueller-Hinton agar medium was prepared at a concentration of 38g/L and supplemented with1%agaragar.Themediumwassterilisedbystandard autoclavingandthenpouredintopetridishes,allowingitto solidifyundisturbed.
Aftersolidification,thepreparedculturebrothwasevenly swabbedontothesurfaceoftheMueller-Hintonagar.Wells of6mmdiameterweremadeintheagar,andtestsamplesat varyingconcentrations(10,20,40,and60µg),labelledII,III, IV, and V, were added to the respective wells. Ampicillin (10mcg)servedasthestandardreferenceandwaslabelledI. The plates were incubated at 37°C for 24 hours. After incubation, the antimicrobial effect was evaluated by measuring the zone of inhibition (in millimetres) around eachwell,withresultsrecordedin table1.

Effectofa) Limosilactobacillusfermentum,b) Escherichiacoli,andc) Candidaalbicans onCu-Allium Sativumnanoparticles

International Research Journal of Engineering and Technology (IRJET) e-ISSN: 2395-0056
Table -1: MeanofzoneofinhibitionobtainedbyCu-Allium Sativum nanoparticles against A) Limosilactobacillus fermentum,B) Escherichiacoli,andC) Candidaalbicans

Fig- 4 : AntimicrobialactivityZoneofinhibitionobtained byCu-AlliumSativum nanoparticlesbywelldiffusion method
ManyresearchershaveshownthatCu-garlicextractshavea great antibacterial activity against Limosilactobacillus fermentum[6]. The phytochemicals present in cu -garlic nanoparticlesareresponsiblefortheirantibacterialactivity
[7].Thesampledemonstratedgreaterantimicrobialactivity againsttheGram-positiveorganismatconcentrationsof 20, 40, and 60µg.Additionally, notable activity was observed against Candidaalbicans at40and60µg,whilenoinhibition zonesweredetectedforGram-negativeorganisms
4. CONCLUSIONS
Bio-synthesisofcoppernanoparticlesusingAlliumsativum (garlic) extract was successfully carried out at room temperature.Duringthesynthesis,biomoleculespresentin thegarlicextractaremainlyresponsibleforthereduction and stabilization of the nanoparticles. Optical properties, compositionalanalysisandfunctionalgroupcontentofassynthesizedcoppernanoparticleswerestudiedusingUV-Vis spectrophotometer and Fourier Transform Infrared Spectroscopy(FTIR)respectively. FTIRanalysisillustrated thepresenceofchieffunctionalgroups;phenol,carbonyland amidegroupsatthesurfaceof CuNPswhichareresponsible forreducingandstabilizingthenanoparticles.
CuNpshavebeenwidelyusedforantimicrobial andbiomedicalproducts.Presentstudyconcludedthat,the CuNpshasstrongantibacterialactivity.Thesignificanceof over results is that CuNps solutions have a significant antibacterial activity against the Gram-positive organism These nanoparticles may capable of entering into the bacterial cell through cell wall and cell membrane, where theymightinhibittheenzymaticactivityandfinallystopped thegrowthanddivisionof bacterial cell.Henceuseof our nanoparticles may help in inhibiting the studied bacterial growth.
The authors wish to thank the management and Principal,TDMNSCollege,T.Kallikulam,Tirunelvelifortheir supporttoundertakethisresearchprogramme.
[1]Parikh,P.,Zala,D.andMakwand,B.A.,2014,Biosynthesis ofcoppernanoparticlesandtheirantimicrobialactivity,KSV University,India.Pp.1-15.
[2]Mousavi Khaneghah,Amin;Hashemi,SeyedMohammad Bagher; Eş, Ismail; Fracassetti, Daniela; Limbo, Sara (2018). Efficacy of Antimicrobial Agents for Food Contact Applications: Biological Activity, Incorporation into Packaging, and Assessment Methods: A Review. Journal of Food Protection, 81(7), 1142–1156. doi:10.4315/0362028X.JFP-17-509
[3] Amatya, Sharmila Pradhan; Pradhan Joshi, Leela. (2020). Bio-Synthesisofcoppernanoparticles(CuNPs)using Garlicextract toinvestigateantibacterialactivity.bibechana, 17013–19. doi:10.3126/bibechana.v17i0.23485
Volume: 13 Issue: 01 | Jan 2026 www.irjet.net p-ISSN: 2395-0072 © 2026, IRJET | Impact Factor value: 8.315 | ISO 9001:2008 Certified Journal | Page143

International Research Journal of Engineering and Technology (IRJET) e-ISSN: 2395-0056
Volume: 13 Issue: 01 | Jan 2026 www.irjet.net p-ISSN: 2395-0072
[4].J.Shikha,J.Ankita,D.Vijaya,Experimentalinvestigation on the synthesis of Copper nanoparticles by chemical reduction method, International Journal of Scientific & EngineeringReaearch,5(2014)973-978
[5] Velsankar, K.; R.M., Aswin Kumar; R., Preethi; V., Muthulakshmi;Sudhahar,S..(2020). GreensynthesisofCuO nanoparticles via Allium sativum extract and its characterizationsonantimicrobial,antioxidant,antilarvicidal activities. Journal of Environmental Chemical Engineering, , 104123–. doi:10.1016/j.jece.2020.104123
[6]Hoglund,K.B.;Barnett,B.K.;Watson,S.A.;Melgarejo,M.B.; Kang,Y.Activityofbioactivegarliccompoundsontheoral microbiome:Aliteraturereview. Gen.Dent. 2020, 68,27–33.
[7]Bhattacharya, S.; Gupta, D.; Sen, D.; Bhattacharjee, C. Processintensificationontheenhancementofallicinyield from Alliumsativum throughultrasoundattenuatednonionic micellar extraction. Chem. Eng. Process. Process Intensif. 2021, 169,108610.